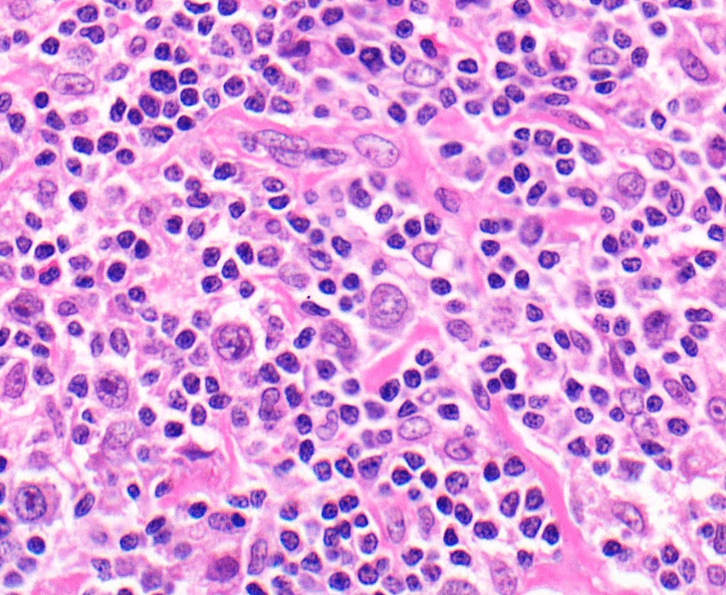

Blood Cancer Awareness Month falls on September each year. Based on the most current figures provided by Bloodwise, the UK’s leading blood cancer research charity, 1 in every 16 males and 1 in every 22 females in the UK will develop blood cancer at some point during their lifetime. This makes it the fifth most common type of cancer in the UK, with 40,000 new blood cancer cases being diagnosed yearly.

Blood cancer occurs when blood cells undergo mutations that cause them to stop developing and multiplying normally. This results in a failure of their usual functions, which ultimately leads to poor health.
Given the vast number of blood cells that our bodies possess, there are over 100 different individual types of blood cancer. Consequently, each type of blood cancer presents differently, requires different treatments and each has a different prognosis. The majority of blood cancers fall within three main groups: lymphoma, leukaemia and myeloma.
The Centre for Haemato-Oncology at Barts Cancer Institute (BCI), Queen Mary University of London, places the emphasis of its research on gaining a clearer understanding of the underlying genetic mutations that lead to the development of blood cancers, particularly leukaemias and lymphomas. The Centre is dedicated to using knowledge of the biology of these cancers to identify novel targets in order to direct the formulation of new treatments for patients.
Lymphoma describes the malignancy of lymphocytes, a type of white blood cell which form part of our immune system. There are two main types of lymphoma, Hodgkin’s lymphoma (HL) and non-Hodgkin’s lymphoma (NHL). Approximately 13,900 new cases of NHL are diagnosed in the UK each year, making it the sixth most common cancer in the UK. HL is much rarer, with about 2,100 new cases diagnosed in the UK each year.
Dr Jessica Okosun, a Group Leader in BCI’s Centre for Haemato-Oncology, is currently focusing on a type of NHL called follicular lymphoma. Dr Okosun’s work looks at understanding the molecular processes involved in the initiation of follicular lymphoma, and the genetic diversity that exists in this cancer type. Whilst it is recognised that genetic diversity exists between tumours in different patients with follicular lymphoma, last year a team of researchers led by Dr Okosun found that this diversity also exists between different tumours in the same patient.
The findings of this study have clinical implications when considering targeted therapy and suggest that the genetic diversity between tumours within the same patient needs to be taken into account to allow for the most effective course of therapy to be utilised.
Leukaemia describes the malignancy of white blood cells, and is a cancer which starts in blood-forming tissue, usually the bone marrow. There are many different types of leukaemia, and they can be described as acute (those which develop fast) or chronic (those which develop more slowly).
One aspect of the research within BCI’s Centre for Haemato-Oncology focuses on understanding cancer stem cells (CSCs), which fuel the disease and are often resistant to current therapies. A team of researchers led by BCI’s Professor Kamil Kranc and Professor Donal O’Carroll (MRC Centre for Regenerative Medicine and Wellcome Centre for Cell Biology, University of Edinburgh) recently identified a novel target that eliminates CSCs in pre-clinical models and patient-derived acute myeloid leukaemia (AML) cells. This research uncovers important information relevant to finding a way to target CSCs, whilst boosting normal blood cell functions. The idea covered in this research may have the potential to be extended to other cancers driven by CSCs and the team hope that their findings will establish a new paradigm in cancer treatment. Find out more about this research here.
In addition, a team co-led by BCI’s Professor Jude Fitzgibbon and the Blizard Institute’s Professors Tom Vulliamy and Inderjeet Dokal is conducting research into the genetic basis of familial AML. This bears hope that families which have an inherited predisposition to AML can be identified, counselled and have their health managed more appropriately. Knowing the genetic makeup of the disease may also mean that treatments can be tailored specifically for the individual patient. Find out more about this research project here.
Blood cancer claims 15,000 lives each year in the UK, making it the third largest cancer killer. Despite this, only 1% of people are “very confident” that they could identify common symptoms of blood cancer (according to a poll of 2,000 British adults conducted by Bloodwise in 2018). Blood Cancer Awareness Month is therefore a vital annual campaign to raise public awareness.
The researchers at the BCI, as part of the Cancer Research UK (CRUK) Barts Centre, are committed to continue to work to understand the biology of blood cancer and harness this knowledge to identify new treatment strategies to help those affected.
For more information on the different types of blood cancer and their symptoms, please visit the Bloodwise and CRUK websites. You can find out more about our blood cancer research here.
Thank you to all of our funders for your continued support of our blood cancer research.
Article co-author: Yee Neng Adaylia Faith Loo, Medical Student
Category: General News
No comments yet